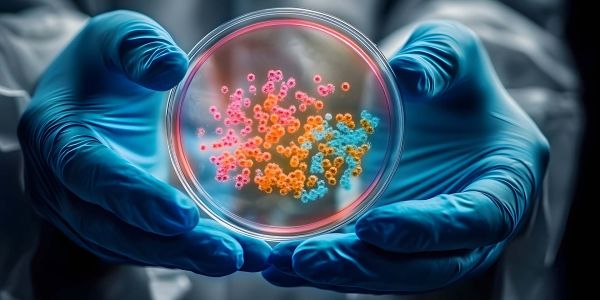

|
|
Riprende l'invio della newsletter dopo la pausa estiva.
Scopri le ultime notizie e gli eventi che si svolgeranno dal 5 all'11 settembre 2024.
Buona lettura! |
|
|
|
|
Mobilità |
|
|

|
|
L’abbonamento UNIPASS consente la libera circolazione sui mezzi del trasporto pubblico urbano e di area urbana di Pavia. |
|
|
Internazionalizzazione |
|
|

|
|
Nell'anniversario del lancio della prima bomba atomica nasce l'alleanza University Presidents for Peace di cui l’Università di Pavia è tra i soci fondatori. |
|
|
Su Flickr |
|
|

|
|
Giunta alla XXXII edizione la Giornata del Laureato rappresenta un importante appuntamento per l'Università di Pavia e i suoi laureati. |
|
|
Su Flickr |
|
|

|
|
Oltre 600 i laureati con lode che hanno ritirato la pergamena durante l’evento. |
|
|
Dicono di noi |
|
|

|
|
Ecco alcuni degli highlight che hanno vista coinvolta l’Università di Pavia nella rassegna stampa, radio e tv del periodo estivo. |
|
|
Medicina |
|
|

|
|
L’eccellenza dell’Università di Pavia e dell’IRCCS Policlinico San Matteo in tema di salute della donna in menopausa. |
|
|
Biologia |
|
|
|
|
Autore il Prof. Davide Sassera, del Dipartimento di Biologia e Biotecnologie dell’Università di Pavia, grazie a una collaborazione con ricercatori della Fondazione IRCCS Policlinico San Matteo, dell'Università di Oslo e del Wellcome Sanger Institute. |
|
|
Riconoscimenti |
|
|

|
|
Un’associazione multidisciplinare che ha l’obiettivo di stimolare e perseguire lo scambio di conoscenze tra Università, enti di ricerca e industria, fornendo valutazioni e raccomandazioni a stakeholder, decisori politici e società. |
|
|
Riconoscimenti |
|
|

|
|
Riconosciuto il valore della ricerca scientifica condotta presso il Laboratorio di Psicobiologia dello Sviluppo del Dipartimento di Scienze del Sistema Nervoso e del Comportamento UniPv e di IRCCS Fondazione Mondino. |
|
|
Riconoscimenti |
|
|

|
|
Si tratta del Therapeutic Idea Award – Biomarker Option assegnato al Prof. Marco Peviani, responsabile del CMNlab (Cellular and Molecular Neuropharmacology Lab) situato presso il Dipartimento di Biologia e Biotecnologie dell'Università di Pavia. |
|
|
Geologia |
|
|

|
|
I risultati dello studio, condotto da un team internazionale guidato dall'Ateneo pavese, sono stati pubblicati sulla rivista internazionale «Nature Geoscience». |
|
|
Ranking |
|
|

|
|
Questo risultato riflette l'impegno costante dell’Ateneo nel creare un ambiente accademico globale e aperto, attirando studenti e docenti da tutto il mondo e aumentando le opportunità di studio e ricerca all'estero. |
|
|
Internazionalizzazione |
|
|

|
|
Dal 23 al 27 settembre 2024 l'Università di Pavia organizzerà sessioni informative, tour, gare sportive, saluti istituzionali, presentazioni di servizi e associazioni, testimonianze di studenti e una parata di bandiere. |
|
|
Su Flickr |
|
|

|
|
Giovedì 11/07 si è tenuto l’Open Day, Porte Aperte all’Università di Pavia, evento di orientamento, pensato per gli studenti delle scuole superiori, si è svolto nelle sedi di Pavia e Cremona. A Porte Aperte docenti, giovani ricercatori e studenti tutor. |
|
|
Studenti |
|
|

|
|
Gli Ambassador avranno il compito di promuovere l’Alleanza, raccontare le opportunità offerte e mostrare cosa significa farne parte. Gli studenti selezionati parteciperanno a una sessione di formazione dedicata che si terrà all’Università di Poitiers. |
|
|
Riconoscimenti |
|
|

|
|
Obiettivo dello studio realizzato al Dipartimento di Matematica: ottimizzare i tempi di attesa dei pazienti sottoposti a TAC. |
|
|
Traguardi |
|
|

|
|
Il 22 luglio il primo traguardo importante per il progetto didattico sull'AI promosso da Università di Pavia, Statale e Bicocca. Ogni anno vagliate più di 1.000 richieste di iscrizione per 180 posti. Circa un terzo degli studenti sono stranieri. |
|
|
Traguardi |
|
|

|
|
Il percorso attivato nel 2022 interamente in lingua inglese. I temi: alte produzioni, salute dell’ambiente, dei produttori agricoli e dei consumatori, in un’ottica di sostenibilità, e secondo una visione integrata One Health. |
|
|
Video |
|
|

|
|
L'evento si è svolto nell'ambito del "Propagazioni Festival 2024", in collaborazione con la Fondazione Casa Museo Antonio Gramsci di Ghilarza e con la Fondazione Gramsci di Roma. |
|
|
In memoria |
|
|

|
|
Alunno del Collegio Fraccaro e laureato all'Università di Pavia nel 1971, è stato allievo del prof. Elio Guido Rondanelli. |
|
|
Sostenibilità |
|
|

|
|
L’Ufficio Azioni di Sostenibilità – OSA dell'Università di Pavia sarà presente in Borgo Ticino con uno stand informativo il 7 e l'8 settembre per presentare il programma del Festival e i propri progetti di sviluppo sostenibile. |
|
|
Mobilità sostenibile |
|
|

|
|
OSA - Office for Sustainable Actions, oltre ad organizzare varie attività durante la Settimana Europea della Mobilità, ha deciso di lanciare un contest fotografico intitolato #IOELAMIABICIUNIPV aperto a tutta la comunità accademica. |
|
|
Erasmus Plus |
|
|

|
|
Gli obiettivi di questo incontro hanno riguardato la raccolta e la discussione dei feedback relativi al processo di autovalutazione interna della PE - Practice Entreprise. |
|
|
Patrimonio culturale |
|
|

|
|
Obiettivo la formazione di studenti provenienti dai corsi di Laurea in Ingegneria Edile-Architettura e Architettura dei tre atenei coinvolti nel progetto: Università di Pavia, Università della Basilicata e Università di Parma. |
|
|
Centro Linguistico UniPV |
|
|

|
|
Dal 30 agosto al 17 settembre 2024 è possibile iscriversi ai Corsi semestrali di Lingua Italiana di livello A1, A2, B1 e B2 organizzati dal Centro Linguistico d'Ateneo per il primo semestre dell'anno accademico 2024/25. |
|
|
Centro Linguistico UniPV |
|
|

|
|
Le iscrizioni sono aperte fino al 15 settembre 2024. |
|
|
Formazione |
|
|

|
|
Tra maggio e luglio si sono tenute presso la palestra centrale del Cus Pavia le lezioni di difesa personale per i dipendenti dell'Università di Pavia. |
|
|
Internazionalizzazione |
|
|

|
|
Lunedì 6 e martedì 7 maggio si è svolta presso il Polo Tecnologico a Pavia e contemporaneamente nelle altre 7 università dell’alleanza Alleanza EC2U la EC2U Makeathon, un contest studentesco a tema innovazione e sostenibilità. |
|
|
Cral Ateneo Pavia |
|
|

|
|
UniPv, tramite il CRAL Ateneo APS, ha partecipato per la prima volta con un atleta, Alessio Discacciati, che con un’ottima prestazione di 50:53 si è classificato primo nella categoria Uomini Juniores (30-34 anni) e ottavo nella classifica generale. |
|
|
CRAL Ateneo Pavia |
|
|

|
|
Dal 26 al 31 agosto 2024 si sono svolti a Giffoni (SA) il 37° Campionato Nazionale Universitario di Tennis e il 3° di Padel ANCIU 2024, riservati ai dipendenti delle Università, organizzati dal CRAL dell’Università degli studi di Salerno. |
|
|
|
Eventi dal 5 all'11.09.2024
|
|
Dal 2 al 6 settembre 2024 |
|
Fisica |
|
|
|
|
Dal 2 al 7 settembre 2024 |
|
Linguistica |
|
|
|
|
7 settembre 2024 |
|
Museo per la Storia dell'Università |
|
|
|
|
7 settembre 2024 |
|
Biblioteca Universitaria di Pavia |
|
|
|
|
Dal 9 al 19 settembre 2024 |
|
Ingegneria |
|
|
|
|
Dal 10 al 13 settembre 2024 |
|
Cremona |
|
|
|
|
10 settembre 2024 |
|
Lectio Magistralis |
|
|
|
|
|
Eventi che richiedono iscrizione
|
|
12 settembre 2024 |
|
Camera di Commercio Pavia |
|
|
|
|
Dal 16 al 19 settembre 2024 |
|
Arti visive e performative |
|
|
|
|
17 settembre 2024 |
|
Formazione |
|
|
|
|
19 settembre 2024 |
|
Ambiente |
|
|
|
|
24 settembre 2024 |
|
Formazione |
|
|
|
|
1 ottobre 2024 |
|
Ingegneria |
|
|
|
|
Dal 9 al 14 dicembre 2024 |
|
Cervello |
|
|
|
|
|
Bandi, Premi e Borse di studio
|

|
|
Scuole di specializzazione |
|
|
|
|

|
|
Call for Applications |
|
|
|
|
|

|
|
Mobilità studentesca |
|
|
|
|

|
|
Teatro |
|
|
|
|
|

|
|
Collegi |
|
|
|
|

|
|
Ricercatori e laureati |
|
|
|
|
|

|
|
Premio di laurea |
|
|
|
|

|
|
Master |
|
|
|
|
|
|
|
|
